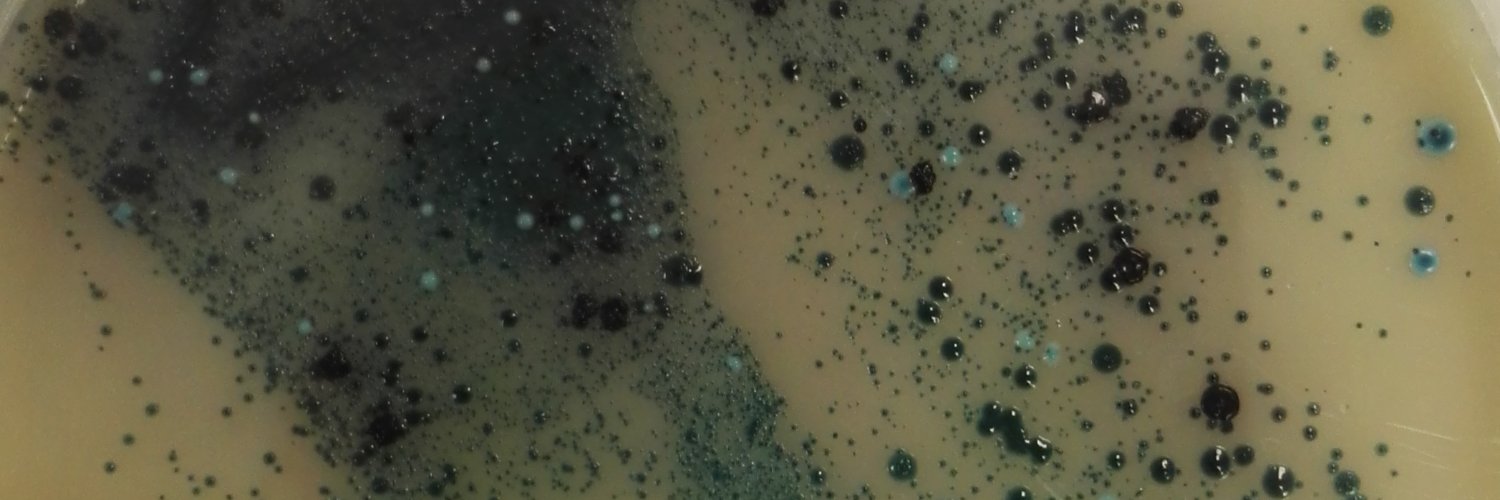
Grace Plahe banner

So many amazing talks @MicrobioSoc, looking forward to more over the next two days! If you missed my poster, never fear, you can still email me any questions 👍 #microsoc22

English
Grace Plahe
10 posts

@GracePlahe
collect and boil ticks for a living, rest of the time dog and beer lover




Absolutely terrifying footage from a ferry carrying passengers escaping the shores of Lake Evia in #Greece.


🚨 #NEPG2020 happening online Friday 13th November! 🚨 FREE registration here: ne-pg.co.uk/whats-on/confe… Special thanks to @_scientistt and @_SciStudio for making our super cool video⬇️

How do temperate #bacteriophages affect the fitness of #Pseudomonas aeruginosa? #PhgOx20V #GIPlahe
